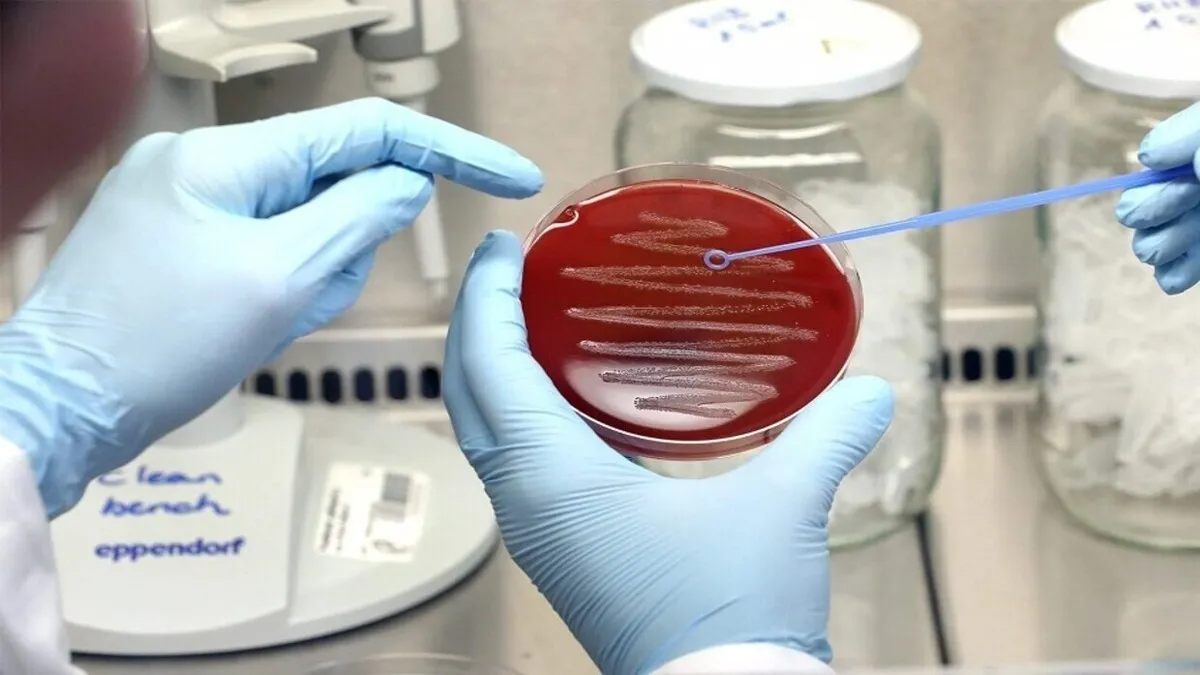

اكتشاف طريقة لمحاربة البكتيريا المقاومة لمضادات الحيوية
أفادت وکالة آنا الإخباریة، وتقول البروفيسورة ماريا زيكوفا: "أظهرت النتائج أن جميع المواد الحيوية التي تمت دراستها يمكن أن تصيب البكتيريا المسببة للأمراض، بالإضافة إلى ذلك، اكتشفنا أن لها تأثير مثبط على كل من الأغشية الحيوية الموجودة لهذه البكتيريا وتكوينها، أي أنها تساعد في منع تكوين مقاومة لمضادات الحيوية".
وقد ركز الباحثون على المواد الحيوية التي حصلوا عليها من المواد الدبالية الطبيعية والجسيمات النانوية الفضية. وتبين أن هذه المواد المبتكرة تستطيع قتل الكائنات الحية الدقيقة وتمنع تكوين الأغشية الحيوية أيضا. أي ليس مستبعدا أن تؤدي هذه النتائج إلى ابتكار حلول جديدة لمكافحة العدوى، وستكون بمثابة خطوة كبيرة في مجال الطب والرعاية الصحية.
ويشير الباحثون إلى أنهم استخدموا أساليب ومعدات متقدمة (الرنين المغناطيسي النووي والمجهر الإلكتروني النافذ) في مختبرات جامعة سيبيريا الطبية لفهم كيفية تفاعل المواد مع الميكروبات الخطيرة، مثل الإشريكية القولونية، والكلبسيلا الرئوية، والمكورات العنقودية الذهبية، والزائفة الزنجارية، وغيرها.
ووفقا للعلماء، يؤدي الاستخدام غير المنضبط لمضادات الحيوية إلى مشكلة عالمية خطيرة - تصبح البكتيريا أكثر مقاومة للأدوية. أحد أسباب بقاء البكتيريا على قيد الحياة هو قدرتها على تكوين الأغشية الحيوية.














